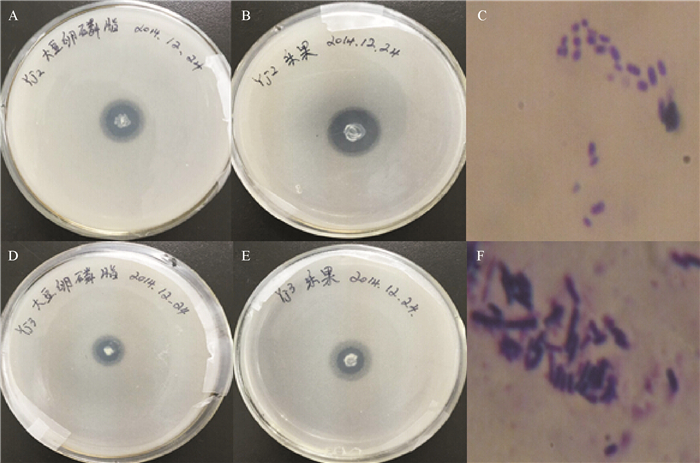

2. 吉林农业大学 农学院,吉林 长春 130118
2. Faculty of Agronomy, Jilin Agricultural University, Jilin 130118, China
在我国,耕地土壤的全磷含量一般为2~11 mg·kg-1,土壤中有机磷一般占土壤全磷的30%~80% [1]。作物对磷肥的利用率也很低,当季利用率一般只有5%~10%[2]。解磷菌能使土壤中难溶性或不溶性的磷转化成易于被植物吸收利用的磷,从而提高土壤的供磷水平[3]。
根据其降解物质的不同解磷菌又分为有机解磷菌和无机解磷菌,解磷菌种类繁多,解磷机制也不尽相同[4]。人们普遍认为,解磷菌对有机磷的分解是通过分泌胞外酶实现的。在土壤缺磷的情况下,微生物会产生各种酶类,如植酸酶、核酸酶和磷酸酶等。这些酶可加速植酸、核酸、磷脂等含磷有机化合物的分解,促进磷素释放。较低的磷含量往往能促使植物根系和微生物分泌大量的磷酸酶,利于有机磷的分解。酸性磷酸酶是细菌和植物根系的产物,碱性磷酸酶仅由土壤中的细菌合成[5],有机磷降解酶是一类水解酶,可水解有机磷酸三酯、有机磷硫酯和有机氟磷酸的各种磷酰键如P—O、P—S和P—F[6]。
目前有效的杀虫剂多为有机磷化合物,这类化合物可以侵入生物的神经系统而致其死亡[7]。乐果(Dimethoate)是广泛使用的有机磷农药之一,为中等毒性,在土壤中很容易沉降聚集,可通过食物链的富集作用转移到人体, 对人体产生危害[8]。本研究从大豆根际土壤中分离到的2株有机磷降解菌株Yj2和Yj3不仅能水解P—O键、降解大豆卵磷脂,同时可以降解二硫代磷酸脂乐果,进一步就菌株对卵磷脂和乐果的降解能力及降解过程中磷酸酶活性与有机磷降解酶的特性进行了研究。这对农田磷素的循环利用以及适时降解剩余的有机磷农药,保护环境方面都有积极的意义,并可为有机磷解磷菌剂的开发与应用提供基础数据。
1 材料与方法 1.1 材料2013年2月,利用对角线布点法,从吉林农业大学大豆试验田(东经125°19′、北纬43°43′)采集大豆根际土壤,4 ℃保存。
40%(w)乐果乳油(上海悦农化工有限公司);Sephadex G-25 Fine层析柱(GE Amersham Biosciences);阳离子交换层析试剂SP Sepharose Fast Flow;层析系统AKTAprime plus(瑞典,型号11-0013-13)。
有机磷培养基:葡萄糖10 g·L-1,硫酸铵0.5 g·L-1,氯化钠0.3 g·L-1,氯化钾0.3 g·L-1,硫酸亚铁0.03 g·L-1,硫酸锰0.03 g·L-1,碳酸钙5 g·L-1,大豆卵磷脂0.2 g·L-1。
LB培养基:胰蛋白胨10 g·L-1,酵母提取物5 g·L-1,NaCl 10 g·L-1。
1.2 方法 1.2.1 菌株的筛选及鉴定取1 g土壤样品,加入100 mL灭菌的有机磷液体培养基,30 ℃、135 r·min-1摇床培养10 d后,取1 mL悬浊液逐级稀释至10-2、10-3、10-4、10-5、10-6,分别取以上各浓度样品100 μL涂布于以卵磷脂为有机磷源的固体培养基上,30 ℃培养24~48 h。选择有较大溶磷圈的单菌落,反复纯化4次,直至形成均一的菌落,将其转至斜面培养至菌苔长出,置于4 ℃保存。
将纯化后的有机磷解磷菌单菌落接种至LB液体培养基中,135 r·min-1、30 ℃恒温培养过夜,12 000 r·min-1、4 ℃离心10 min,收集菌体。进行细菌总DNA的提取,方法参照文献[9]。以菌株总DNA为模板,利用细菌16s rDNA通用引物[10]进行PCR,引物序列: R: 5′-AAGGAGGTGATCCAGCC-3′,F: 5′-AGAGTTTGATCCTGGCTCAG-3′。反应条件:98 ℃预变性5 min;94 ℃变性45 s,57 ℃退火45 s,72 ℃延伸2 min,33个循环;72℃延伸7 min,4 ℃保存。反应体系:模板0.2 μL,上下游引物各0.2 μL,LA Taq Buffer 2 μL,dNTPs (2.5 mmol·L-1)2 μL,eTaq聚合酶0.2 μL,无菌去离子水补至20 μL。PCR产物经10 g·L-1琼脂糖凝胶电泳鉴定。同时将产物纯化回收后,送上海生物工程有限公司进行测序。测序序列与GenBank进行BLAST相似性比较,并利用Mega 5.10与相关菌株的16S rDNA构建系统发育树。
1.2.2 菌株生长条件的优化及菌体生长曲线的测定以有机磷培养基为基础,对不同碳源(葡萄糖、蔗糖、甘露糖)、氮源(蛋白胨,硝酸铵,硫酸铵)及pH(7、8、9)进行三因素三水平正交试验,挑取单菌落接种于5 mL LB培养基中,D600 nm=0.6时,种子液按体积分数1%的接种量接种于以大豆卵磷脂为有机磷源的培养基中,30 ℃、150 r·min-1培养72 h,每隔6 h取样,利用分光光度计测定D600 nm。采用Excel 2007进行分析,进而确定最佳的碳源、氮源及pH。
以优化得到的最佳培养条件为基础,分别以大豆卵磷脂、乐果为有机磷源的未接菌培养基为对照,另取150 μL种子液分别接入150 mL有机磷培养基,30 ℃、150 r·min-1进行培养,每12 h取1次样,测定D600 nm。
1.2.3 酶活性的测定酸性磷酸酶和碱性磷酸酶活性的测定参照伊鋆[11]的方法进行,菌体培养同1.2.2,每隔12 h吸取1 mL发酵液,加入pH 6.5的MUB试剂,再加1 mL 0.025 mol·L-1对硝基苯磷酸二钠溶液,震荡10 s。37 ℃反应1 h后,加入1 mL 0.5 mol·L-1氯化钙溶液和4 mL 0.5 mol·L-1氢氧化钠溶液,震荡并过滤悬液,将滤液在420 nm处比色;碱性磷酸酶测定时所用MUB试剂pH为8.0,其他步骤同酸性磷酸酶测定方法。磷酸酶活性以每分钟D420 nm增加0.001计为1个酶活力单位(U)。
有机磷降解酶活性的测定参照文献[12]的方法。培养菌液,每隔12 h取菌液0.9 mL,8 000 r·min-1离心2 min,去上清,用0.9 mL pH 7.5的20 mmol·L-1的Tris-HCl悬浮为粗酶液。
取0.1 mL的0.05 mol·L-1乐果溶液、0.9 mL的粗酶液于比色管中,25 ℃条件下反应45 min,加入1 mL 10%(φ)三氯乙酸终止反应,再加入1 mL 10%(w)碳酸钠溶液显色,测定D405 mm。以D405 mm增加0.001计为1个酶活力单位(U)。
1.2.4 有机磷降解酶的纯化将D600 nm=0.6的Yj2种子液以体积分数为1‰的量接入1 L以卵磷脂为磷源的有机磷培养基中,30 ℃,150 r·min-1,培养48 h后4 ℃、4 000 r·min-1离心30 min收集菌体。每克菌以15 mL 20 mmol·L-1的Tris-HCl(pH 7.5)缓冲液悬浮,每毫升溶液加入1 mg溶菌酶充分搅拌后4 ℃静置30 min,冰浴超生波破碎(1 400 W、工作5 s、间歇9 s、50次循环)。4 ℃下10 000 r·min-1离心20 min。取上清按硫酸铵质量浓度为100、200、400和650 g·L-1进行逐步沉淀。沉淀用40 mL的Tris-HCl(20 mmol·L-1 pH 7.5)缓冲液悬起后,进行Sephadex G-25 Fine层析柱脱盐,取流川液再进行阳离子交换层析,分别以含有0.1、0.2和0.5 mol·L-1 NaCl的Tris-HCl(20 mmol·L-1,pH 7.5)进行阶段洗脱;利用层析系统检测流出组分。取流川液及出峰时的流出液体进行有机磷降解酶活力测定,酶活力测定方法同1.2.3。SDS-PAGE检测分离结果。
2 结果与分析 2.1 有机磷解磷菌的分离与鉴定以大豆卵磷脂和乐果为磷源,检测和鉴定从吉林农业大学大豆试验田土壤中分离的2株具有明显解磷效果的菌株,菌株分别命名为Yj2和Yj3。2株菌在以大豆卵磷脂(图 1A、1D)和乐果(图 1B、1E)为有机磷源的固体培养基中生长时,均有明显透明圈产生。100倍油镜观察Yj2(图 1C)和Yj3(图 1F)发现,2株菌均为杆状。
|
图 1 Yj2和Yj3溶磷效果和菌株形态 Figure 1 Effects on phosphorus-solubilizing and morphology of strains Yj2 and Yj3 A、B分别为以大豆卵磷脂和乐果为磷源时Yj2的溶磷效果;C:Yj2的菌株形态(100×油镜);D、E分别为以大豆卵磷脂和乐果为磷源时Yj3的溶磷效果;F:Yj3的菌株形态(100×油镜)。 |
分别以菌株Yj2和Yj3的基因组DNA为模板,利用细菌16S rDNA引物进行PCR扩增,得到长度约为1 500 bp的扩增产物(图 2A)。将该片段与pMD18-T载体连接,并转化大肠埃希菌Escherichia coli JM109感受态细胞,提取阳性菌株质粒并酶切,结果如图 2B所示,酶切片段与基因组DNA为模板PCR扩增产物大小一致,回收该目的片段并测序。将测序序列利用Genbank DNA数据库进行BLAST相似性比较。结果表明菌株Yj2 16S rDNA基因序列与Acinetobacter genomosp. 13(FJ694759.1)相似性较高,相似性为99%,因此Yj2被鉴定为醋酸钙不动杆菌Acinetobacter sp.;菌株Yj3 16S rDNA基因序列与Bacillus sp. B2101(JX266369.1)有较高的相似性,相似性为99%,因此Yj3被鉴定为芽孢杆菌Bacillus sp.。

|
图 2 Yj2和Yj3 16S rDNA基因的克隆及重组质粒的酶切结果 Figure 2 Amplification of 16S rDNA gene and restriction enzyme digestion of recombinant plasmids of Yj2 and Yj3 M: DL 2000 Marker, 1、3为Yj2,2、4为Yj3;A:PCR产物,B:酶切结果。 |
利用Mega 5.10构建Yj2和Yj3基于16S rDNA基因序列的系统发育树。由图 3A可知,与Yj2相似性较高的11个菌株的16S rDNA序列在系统发育树中主要分为2个大的分支。其中,Yj2属于第1个分支。由图 3B可知,与Yj3同源性较高的11株菌的16S rDNA序列在系统发育树中没有形成明显的独立分支。

|
图 3 Yj2和Yj3基于16S rDNA序列构建的系统发育树 Figure 3 Phylogeny tree of 16S rDNA sequence from Yj2 and Yj3 |
对Yj2和Yj3菌株生长条件中碳源、氮源、pH进行优化。Yj2的最佳碳源为葡萄糖,氮源为硫酸铵,pH为8。Yj3的最佳碳源为葡萄糖,氮源为蛋白胨,pH为9。
以大豆卵磷脂为磷源时,Yj2和Yj3的生长曲线见图 4A,Yj2和Yj3菌体生长曲线均呈现先增加后下降的趋势。Yj2在36 h菌体生长最旺盛,之后呈现下降趋势。Yj3在48 h菌体生长最旺盛,D600 nm为0.516,之后呈下降趋势。以乐果为磷源时,Yj2和Yj3的生长曲线见图 4B,Yj2和Yj3菌体生长曲线均呈现先增加后下降的趋势。Yj2在60 h菌体生长量达到最大,D600 nm为0.579,之后呈下降趋势。Yj3在48h菌体生长量达最大,之后呈现下降趋势。72 h内Yj2的菌体生长情况稍优于Yj3。

|
图 4 以大豆卵磷脂和乐果为磷源时Yj2和Yj3的生长曲线 Figure 4 Growth curve of Yj2 andYj3 using soy lecithin dimethoate as phosphorus source |
以乐果为磷源测定Yj2和Yj3酸性磷酸酶、碱性磷酸酶与有机磷降解酶的酶活性。Yj2和Yj3的酸性磷酸酶活性均呈先增长后下降的趋势(图 5A),且分别在60和48 h出现峰值,酶活性分别为566和483 U。而且,72 h时Yj2酸性磷酸酶活性高于Yj3。

|
图 5 乐果为磷源时Yj2和Yj3的酸性磷酸酶活性、碱性磷酸酶活性和有机磷降解酶活性测定 Figure 5 The enzyme activity of acid phosphatase, alkaline phosphatase and organophosphorus degradation of Yj2 and Yj3 using dimethoate as phosphorus source |
Yj2和Yj3的碱性磷酸酶活性也呈先增长后下降的趋势(图 5B),峰值出现的时间分别与酸性磷酸酶相同,酶活性分别为178和275 U。在72 h内,酸性磷酸酶活性和碱性磷酸酶活性交替增加,但最大值时的酸性磷酸酶活性要高于碱性磷酸酶活性。
Yj2和Yj3的有机磷降解酶活性亦呈先增长后下降的趋势(图 5C),Yj2峰值出现的时间与酸性磷酸酶相同,Yj3则在36 h出现峰值,最大酶活性分别为232和408 U。且72h内Yj2有机磷降解酶活性总是低于Yj3。
2.4 有机磷降解酶的分级纯化及酶活性测定为了进一步明确Yj2和Yj3菌株中有机磷降解酶的特性,收集以乐果为磷源、生长60 h的Yj2所有菌体和48 h的Yj3所有菌体,超声波破碎后,进行硫酸铵沉淀以及硫酸铵沉淀+阳离子交换层析分离纯化,并对有机磷降解酶活性进行测定。结果表明,两者均在65%(w)硫酸铵沉淀中测得有机磷降解酶的活性,过G-25脱盐柱后,在阳离子交换层析过程中,两者在0.2 mol·L-1氯化钠洗脱液中酶活性均较强。以SDS-PAGE检测蛋白结果显示Yj2(图 6A)和Yj3(图 6B)纯化的蛋白均为单一条带。

|
图 6 Yj2和Yj3有机磷降解酶纯化结果的SDS-PAGE Figure 6 SDS-PAGE of purified organophosphorus degradation enzyme of Yj2 and Yj3 M为蛋白Marker,1为流川液,2~4分别表示0.1、0.2、0.5 mol·L-1 NaCl; A:Yj2, B:Yj3。 |
对分级纯化的酶液进行酶活力测定,结果见表 1。Yj2粗酶、硫酸铵沉淀以及硫酸铵沉淀+阳离子交换洗脱液有机磷降解酶的比活力分别为57.41、77.25和600.00。提纯后的酶活性均有所提高,硫酸铵沉淀+阳离子交换层析酶提纯是硫酸铵沉淀的7.77倍,硫酸铵沉淀为粗酶的1.35倍。Yj3粗酶、硫酸铵沉淀以及硫酸铵沉淀+阳离子交换洗脱液有机磷降解酶的比活力分别为60.17、92.05和466.48。提纯后的酶活力分别都提高了一定的倍数,硫酸铵沉淀+阳离子交换层析酶提纯是硫酸铵沉淀的5.07倍,硫酸铵沉淀为粗酶的1.53倍。
|
|
表 1 有机磷降解酶分级纯化的酶活力分析 Table 1 Classification and purification of organophosphate degradation enzyme activity analysis |
长期施用在田间的磷肥、农药以及植物根际残留的有机磷化合物都是植物不能吸收利用的难溶无效态磷,不但造成了土壤中磷素的积累,也对环境造成了极大的污染。解磷微生物可以有效地分解土壤中的无效态磷,释放植物可以吸收利用的磷素[13],从而提高土壤供磷水平。段雪梅等[14]从太湖有机聚集体上分离纯化出1株琼氏不动杆菌Acinetobacter junii pjj-1,发现其对有机磷具有降解作用。同时有研究表明,假单胞菌属Pseudomonas sp. LPx[15]、节杆菌属Arthrobacter sp. L3[16]、伯克霍尔德氏菌属Burkholderia sp. CP7[17]、甲基杆菌属Methylobacterium sp.MAP-2[18]和寡养单胞菌Stenotrophomonas sp.PF32 [19]等菌株对有机磷农药乐果、毒死蜱、甲胺磷和甲基对硫磷也有较好的降解作用。
本研究从大豆根际土壤中分离得到2株对卵磷脂和乐果均有较好降解能力的菌株,鉴定并分别命名为醋酸钙不动杆菌Acinetobacter Yj2和芽孢杆菌Bacillus Yj3。对Yj2和Yj3的生长条件优化结果表明,2株菌株最佳碳源均为葡萄糖。这与赵小蓉等[20]研究发现节杆菌1TCRi7只有在葡萄糖为碳源时才具有溶磷能力的试验结果一致。陈燕飞等[21]研究表明大肠埃希菌和金黄色葡萄球菌Staphyloccocus aureus的最佳生长pH为7,而Yj2和Yj3的最佳生长pH分别为8和9。目前,关于酸性磷酸酶与碱性磷酸酶特性的研究已有较多报道[22-23]。丁洪等[23]的试验中,大豆植株的酸性磷酸酶活性最高为85.19 U。闫建国等[24]发现,在久效磷的作用下,降解菌的碱性磷酸酶活性最高为350 U。本试验对乐果为磷源时Yj2和Yj3的酸性磷酸酶和碱性磷酸酶的活性测定结果表明,0~72 h内,Yj2的酸性磷酸酶和碱性磷酸酶活性均在60 h时出现最大值,分别为566和178 U。Yj3的酸性磷酸酶和碱性磷酸酶活性均在48 h时出现最大值,分别为483和275 U。
由于部分有机磷降解酶可以降解有机磷农药,又称为有机磷农药降解酶。Munnecke[25]发现有机磷农药降解酶的降解效果远胜于微生物本身,特别是对低浓度农药的降解效果更好。因此,有机磷农药降解酶对农药的降解已被公认为是消除农药残留的最有潜力的新方法[26]。本试验对乐果为磷源时Yj2和Yj3的有机磷降解酶利用硫酸铵沉淀法和硫酸铵沉淀+阳离子交换层析法进行纯化及酶活性测定,结果表明,72 h内Yj2和Yj3有机磷降解酶分别在60和36 h出现最大值,分别为232和408 U。Yj2经硫酸铵沉淀和硫酸铵沉淀+阳离子交换层析提纯后的酶活力分别为粗酶活力的1.35和7.77倍;Yj3提纯后的酶活力分别为粗酶活力的1.53和5.07倍。纯化出的能够降解乐果的有机磷降解酶均与阳离子交换柱结合,带正电荷,这与刘玉焕等[27]从曲霉菌中分离纯化出有机磷农药降解酶性质相同。
本试验从大豆根际土壤中筛选并纯化得到了2株具有稳定降解有机磷化合物的菌株,Yj2为醋酸钙不动杆菌Acinetobacter sp.、Yj3为芽孢杆菌Bacillus sp.,2株菌既能降解大豆卵磷脂,又能降解有机磷农药乐果。Yj2的最佳培养条件为葡萄糖、硫酸铵和pH 8。Yj3的最佳培养条件为葡萄糖、蛋白胨和pH 9。以大豆卵磷脂为有机磷源时Yj3的菌体生长情况稍优于Yj2,以乐果为有机磷源时Yj2的菌体生长情况稍优于Y3。Yj2酸性和碱性磷酸酶活性整体高于Yj3,有机磷降解酶的活性低于Yj3。通过硫酸铵沉淀法和硫酸铵沉淀+阳离子交换层析法,分别从Yj2和Yj3菌体中纯化获得了有机磷降解酶。
| [1] |
WANG Y, YE X S, DING G D, et al. Overexpression of phyA and appA genes improves soil organic phosphorus utilisation and seed phytase activity in Brassica napus[J]. Plos one, 2013, 8(4): 1-9. (  0) 0) |
| [2] |
杜育梅, 刘国道. 植物利用磷素的有效性研究进展[J]. 华南热带农业大学学报, 2007, 1(2): 41-47. DOI:10.3969/j.issn.1674-7054.2007.02.010 (  0) 0) |
| [3] |
SHARMA S B, SAYYED R Z, TRIVEDI M H, et al. Phosphate solubilizing microbes: Sustainable approach for managing phosphorus deficiency in agricultural soils[J/OL]. Springer Plus, 2013, 2: 587-601. http://www.springerplus.com/content/2/1/587.
(  0) 0) |
| [4] |
YI Y M, HUANG W Y, GE Y. Exopolysaccharide: A novel important factor in the microbial dissolution of tricalcium phosphorus[J]. World J Microbiol Biotech, 2008, 24(7): 1059-1065. DOI:10.1007/s11274-007-9575-4 (  0) 0) |
| [5] |
刘渊, 李喜焕, 孙星, 等. 磷胁迫下大豆酸性磷酸酶活性变化及磷效率基因型差异分析[J]. 植物遗传资源学报, 2012, 13(4): 521-528. DOI:10.3969/j.issn.1672-1810.2012.04.003 (  0) 0) |
| [6] |
问县芳, 袁永泽, 习海玲, 等. 一种新型有机磷降解酶的二异丙基氟磷酸酯水解特性研究[J]. 华中师范大学学报, 2013, 47(1): 53-56. DOI:10.3969/j.issn.1000-1190.2013.01.013 (  0) 0) |
| [7] |
SALMAN A, FARD A T, NASIR A, et al. Comparative analysis of organophosphate degrading enzymes from diverse species[J]. Bioinformation, 2010, 5(2): 67. DOI:10.6026/bioinformation (  0) 0) |
| [8] |
黄雅, 李政一, 赵博生. 有机磷农药乐果降解的研究现状与进展[J]. 环境科学与管理, 2009, 43(4): 20-24. DOI:10.3969/j.issn.1673-1212.2009.04.007 (  0) 0) |
| [9] |
萨姆克鲁斯J拉塞尔. 分子克隆实验指南[M]. 3版. 北京: 科学出版社, 2002: 8.
(  0) 0) |
| [10] |
BAKERMANS C, MADSEN E. Diversity of 16S rDNA and naphthalene dioxygenase genes from coal-tar-waste-contaminated aquifer waters[J]. Microb Ecol, 2002, 44(2): 95-106. (  0) 0) |
| [11] |
伊鋆. 高效解磷细菌的筛选及解磷机理的研究[D]. 大连: 大连理工大学, 2011: 30
(  0) 0) |
| [12] |
金彬明, 刘佳明. 海洋微生物有机磷降解酶的纯化与性质研究[J]. 中国微生态学杂志, 2007, 19(1): 37-39. DOI:10.3969/j.issn.1005-376X.2007.01.015 (  0) 0) |
| [13] |
伍宁丰, 梁果义, 邓敏捷, 等. 有机磷农药降解酶及其基因工程研究进展[J]. 生物技术通报, 2003(5): 9-12. DOI:10.3969/j.issn.1002-5464.2003.05.003 (  0) 0) |
| [14] |
段雪梅, 冯胜, 王小冬, 等. 一株分离自太湖有机聚集体上的有机磷降解细菌的鉴定及其降解特性研究[J]. 农业环境科学学报, 2008, 27(2): 741-747. DOI:10.3321/j.issn:1672-2043.2008.02.062 (  0) 0) |
| [15] |
肖佳沐, 袁海平, 楼紫阳, 等. 一株乐果降解菌的筛选、鉴定及其降解特性研究[J]. 环境污染与防治, 2010, 32(12): 67-71. DOI:10.3969/j.issn.1001-3865.2010.12.015 (  0) 0) |
| [16] |
BHADBHADE B J, SARNAIK S S, KANEKAR P P. Biomineralization of an organophosphorus pesticide, monocrotophos, by soil bacteria[J]. J Appl Microbiol, 2002, 93(2). (  0) 0) |
| [17] |
史延华. CP1菌株的分离、筛选及其对毒死蜱的降解[J]. 微生物学通报, 2011, 38(9): 1331-1338. (  0) 0) |
| [18] |
王莉. Hyphomicrobium sp.MAP-1菌株修复甲胺磷乙酰甲胺磷和水胺硫磷污染土壤的实验研究[J]. 农业环境科学学报, 2013, 32(1): 81-87. (  0) 0) |
| [19] |
许育新, 冯昭中, 陆鹏, 等. 甲基对硫磷降解菌PF32的分离鉴定及其降解特性研究[J]. 农药学学报, 2009, 11(3): 329-334. DOI:10.3969/j.issn.1008-7303.2009.03.008 (  0) 0) |
| [20] |
赵小蓉, 林启美, 李保国. C、N源及C/N比对微生物溶磷的影响[J]. 植物营养与肥料学报, 2002, 8(2): 197-204. DOI:10.3321/j.issn:1008-505X.2002.02.013 (  0) 0) |
| [21] |
陈燕飞. pH对微生物的影响[J]. 太原师范学院学报(自然科学版), 2009, 8(3): 121-124. DOI:10.3969/j.issn.1672-2027.2009.03.032 (  0) 0) |
| [22] |
钟传青, 黄为一. 不同种类解磷微生物的溶磷效果及其磷酸酶活性的变化[J]. 土壤学报, 2005, 42(2): 286-293. DOI:10.3321/j.issn:0564-3929.2005.02.017 (  0) 0) |
| [23] |
丁洪, 李生秀, 郭庆元, 等. 酸性磷酸酶活性与大豆耐低磷能力的相关研究[J]. 植物营养与肥料学报, 1997, 3(2): 123-128. DOI:10.3321/j.issn:1008-505X.1997.02.005 (  0) 0) |
| [24] |
闫建国, 汝少国, 王蔚. 久效磷对黄鳝乙酰胆碱酯酶、羧酸酯酶和磷酸酶活性的影响[J]. 安全与环境学报, 2006, 6(3): 61-63. DOI:10.3969/j.issn.1009-6094.2006.03.019 (  0) 0) |
| [25] |
MUNNECKE D M. Enzymatic detoxification of waste organophosphorus pesticides[J]. J Agric Food Chem, 1980, 28(1): 105-111. DOI:10.1021/jf60227a025 (  0) 0) |
| [26] |
伍宁丰, 邓敏捷, 史秀云, 等. 一种新的有机磷降解酶的分离纯化及酶学性质研究[J]. 科学通报, 2003, 48(23): 2446-2450. DOI:10.3321/j.issn:0023-074X.2003.23.008 (  0) 0) |
| [27] |
刘玉焕, 钟英长. 华丽曲霉Z58有机磷农药降解酶的纯化和性质[J]. 微生物学报, 2000, 40(4): 430-434. DOI:10.3321/j.issn:0001-6209.2000.04.016 (  0) 0) |
 2016, Vol. 37
2016, Vol. 37



